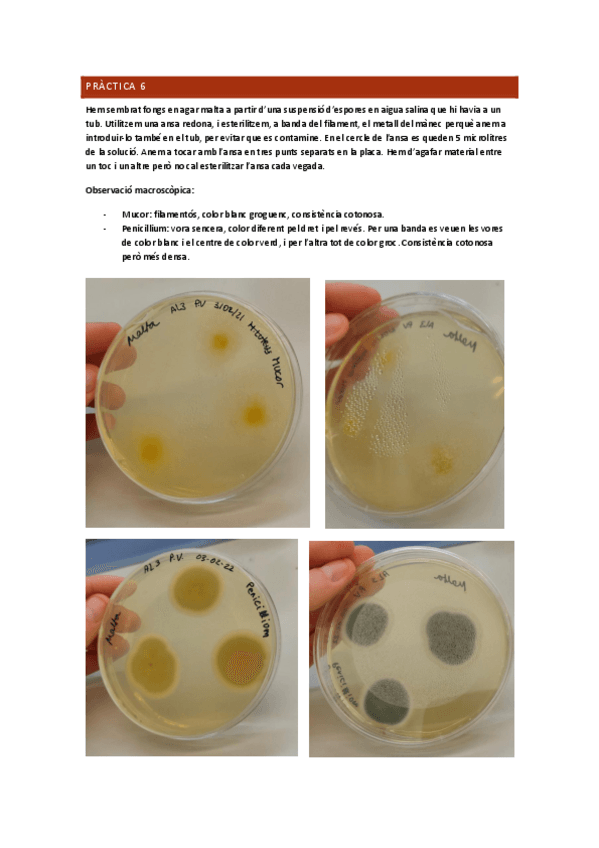

@Wuoworld
243 Publicaciones
7.72k Interacciones
8 Seguidores
1 Siguiendo
Lista de publicaciones de Wuoworld
He publicado nuevos trabajos de 3º Experimentación Integrada en Biología: Qüestionari-zoologia.pdf
He publicado nuevos trabajos de 3º Experimentación Integrada en Biología: Qüestionari-microbiologia.pdf
apuntes
-
Apunts teoria complets 2n Quadrimestre
He publicado nuevos apuntes de 3º Fisiología Animal: Apunts teoria complets 2n Quadrimestre
apuntes
-
Apunts teoria complets 1er Quadrimestre
He publicado nuevos apuntes de 3º Fisiología Animal: Apunts teoria complets 1er Quadrimestre
practicas
-
Pràctiques
He publicado nuevos practicas de 3º Microbiología: Pràctiques
apuntes
-
Apunts teoria complets 1er Quadrimestre
He publicado nuevos apuntes de 3º Microbiología: Apunts teoria complets 1er Quadrimestre
apuntes
-
Temari complet
He publicado nuevos apuntes de 3º Paleontología: Temari complet